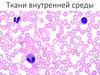
Ткани внутренней среды

Похожие презентации:
Ткани внутренней среды
1. ТКАНИ ВНУТРЕННЕЙ СРЕДЫ
2.
СОЕДИНИТЕЛЬНЫЕТКАНИ
ВОЛОКНИСТЫЕ
(СОБСТВЕННО
СОЕДИНИТЕЛЬНЫЕ)
рыхлая и плотная
КРОВЕТВОРНЫЕ
миелоидная,
лимфоидная
СО
СПЕЦИАЛЬНЫМИ
СВОЙСТВАМИ
КРОВЬ,
ЛИМФА
жировая, ретикулярная
пигментная,
слизистая (эмбриональная)
СКЕЛЕТНЫЕ
(ОПОРНЫЕ)
хрящевая. костная,
дентин, цемент
3.
В СООТВЕСТВИЕ С КОНСИСТЕНЦИЕЙ ОСНОВНОГОВЕЩЕСТВА РАЗЛИЧАЮТ:
1. СОБСТВЕННО СОЕДИНИТЕЛЬНАЯ ТКАНЬ
(ЖИДКОЕ ОСНОВНОЕ ВЕЩЕСТВО);
РЫХЛАЯ ВОЛОКНИСТАЯ СОЕДИНИТЕЛЬНАЯ ТКАНЬ;
КРОВЬ;
ЛИМФА.
2.
3.
ХРЯЩ
(ТВЕРДОЕ И ЭЛАСТИЧНОЕ ОСНОВНОЕ ВЕЩЕСТВО);
ОПОРНЫЕ
ЦЕМЕНТ, КОСТЬ, ДЕНТИН
ТКАНИ
(ОБЫЗВЕСТВЛЕННОЕ ОСНОВНОЕ ВЕЩЕСТВО).
4.
Понятие ткани «внутренней среды» объединяет разнообразные построению и функциям ткани. Целесообразно включать в данную группу только те
ткани, которые по своим основным физиологическим свойствам создают
внутреннюю среду для метаболических реакций, обеспечивают постоянство
состава внутренней среды организма, выполнение защитных функций организма.
Внутренняя среда организма представлена –
рыхлой волокнистой соединительной тканью, тканевой (интерстициальной)
жидкостью, лимфой, кровью, состав и свойства, которых теснейшим образом
связаны между собой.
•Между кровью, волокнистой соединительной тканью и межтканевой жидкостью
происходят постоянный обмен веществ, несущей растворимые в ней продукты
обмена, гормоны, газы, биологически активные вещества; доставка клеточных
элементов. Следовательно, внутренняя среда организма представляет собой
единую систему транспорта, включающую общее кровообращение и движение в
последовательной цепи:
КРОВЬ – ТКАНЕВАЯ ЖИДКОСТЬ - РЫХЛАЯ СОЕДИНИТЕЛЬНАЯ ТКАНЬ –
ТКАНЬ (КЛЕТКА) – ТКАНЕВАЯ ЖИДКОСТЬ – ЛИМФА – КРОВЬ.
5.
ФУНКЦИИ СОЕДИНИТЕЛЬНЫХ ТКАНЕЙТКАНИ,
СОЗДАЮЩИЕ
ВНУТРЕННЮЮ
СРЕДУ ДЛЯ
МЕТАБОЛИЧЕСКИХ
РЕАКЦИЙ,
ОБЕСПЕЧИВАЮТ
ПОСТОЯНСТВО
СОСТАВА
ВНУТРЕННЕЙ
СРЕДЫ,
ВЫПОЛНЕНИЕ
ЗАЩИТНЫХ
ФУНКЦИЙ
ТРОФИЧЕСКАЯ
ДЫХАТЕЛЬНАЯ (ГАЗООБМЕН)
РЕГУЛЯТОРНАЯ
ЗАЩИТНАЯ
ТРАНСПОРТНАЯ
ОПОРНАЯ, МЕХАНИЧЕСКАЯ
6.
СВОЙСТВА СОЕДИНИТЕЛЬНЫХТКАНЕЙ
РАЗВИТИЕ ИЗ МЕЗЕНХИМЫ
ВЫСОКОЕ СОДЕРЖАНИЕ
МЕЖКЛЕТОЧНОГО ВЕЩЕСТВА
РАЗНООБРАЗИЕ КЛЕТОЧНЫХ
ЭЛЕМЕНТОВ
АПОЛЯРНОСТЬ КЛЕТОК
(гр. средняя заполняющая
масса)
Эмбриональная ткань,
часть среднего
зародышевого листка –
мезодермы.
Клеточные элементы
образуются в результате
дифференцировки
дерматоиа, склеротома,
висцерального и
париетального листков
спланхнотома
7.
КРО
ОВ
ВЬ
Ь
КР
8.
СИСТЕМА КРОВИ СОСТОИТ(предложено Г.Ф. Лангом)
КРОВИ;
ОРГАНОВ КРОВЕТВОРЕНИЯ;
СОЕДИНИТЕЛЬНАЯ ТКАНЬ
(ткань внутренней,
метаболической среды)
ОРГАНОВ КРОВЕРАЗРУШЕНИЯ;
АППАРАТА РЕГУЛЯЦИИ
(кроветворения и кроверазрушения)
КРОВЕТВОРНЫЕ ТКАНИ
КРОВЬ, ЛИМФА
ОСОБЕННОСТИ КРОВИ:
• все составные части
образуются за пределами
сосудистого русла;
• межклеточное вещество
является жидким;
• ткань постоянно находится
в движении.
МИЕЛОИДНАЯ
ЛИМФОИДНАЯ
9.
К Р О В Ь(состав)
ФОРМЕННЫЕ ЭЛЕМЕНТЫ КРОВИ
40-48%
МЕЖКЛЕТОЧНОЕ
ВЕЩЕСТВО
(ПЛАЗМА)
52-60%
КЛЕТКИ
(ЛЕЙКОЦИТЫ)
НЕКЛЕТОЧНЫЕ
ЭЛЕМЕНТЫ
ГРАНУЛОЦИТЫ
АГРАНУЛОЦИТЫ
НЕЙТРОФИЛЫ
60-75%
ЭОЗИНОФИЛЫ
3-5%
БАЗОФИЛЫ
0-1%
ЭРИТРОЦИТЫ
Муж 4,5-5,5 10¹²л
Жен 3,7-4,5 10¹²л
МОНОЦИТЫ
6-8%
ЛИМФОЦИТЫ
20-35
КРОВЯНЫЕ
ПЛАСТИНКИ
200-400 тыс/мл
10.
ПЛАЗМА КРОВИ(50-60% объема крови)
Вода
(90%)
Органические
ФУНКЦИИ ПЛАЗМЫ КРОВИ:
вещества
•ТРОФИЧЕСКАЯ;(8-9%)
•РЕГУЛЯТОРНАЯ;
Неорганические
вещества
(0,9-1%)
•ЗАЩИТНАЯ;
•ГОМЕОСТАТИЧЕСКАЯ;
Глобулины
Альбумины
альфа и бета
(масса 70 000 дальтон) •ОБЕСПЕЧЕНИЕ ПРОЦЕССОВ
СВЕРТЫВАНИЯ;(масса 450 000 дальтон)
4-5%
3%
поддерживают
•УЧАСТИЕ В ГАЗООБМЕНЕ;
переносят ионы металлов
онкотическое давление,
переносят гормоны,
ионы, ряд
метаболитов.
и липиды
•СТАБИЛЬНОЕ Ph (7,36)
ЗА СЧЕТ
(липопротеиновые
БУФЕРНЫХ СИСТЕМ комплексы)
Белки системы комплемента
Участие в неспецифических
защитных реакциях
(цитотоксическое действие; хемотаксическая активность;
участие в анафилаксии;
участие в фагоцитозе)
Фибриноген
(масса 340 000дальтон)
0,2-0,4%
обеспечивает
процессы
свертывания крови
11.
Реакция плазмы крови взрослых слабощелочная, 7,35—7,40.Для плодов и новорожденных характерен сдвиг реакции плазмы крови в кислую сторону
— ацидоз.
Наиболее выраженный ацидоз наблюдается сразу после рождения, в течение суток
после рождения постепенно снижаясь. Близкие ко взрослым величины рН
устанавливаются в течение 3—5 суток.
Белки в плазме крови плодов содержатся в меньшей концентрации, чем у взрослого. у
новорожденных — в среднем 56 г/л. Снижение концентрации белков к концу первого
месяца (в среднем до 48 г/ л ) сменяется постепенным увеличением их количества,
которое к 3—4 годам достигает нормы взрослых (70-80г/л)
У новорожденных отмечается относительно более высокий уровень гамма-глобулинов.
Это обусловлено вероятно, тем, что они проходят через плацентарный барьер, и плод
получает их от матери. После рождения происходит расщепление полученных от матери
гамма-глобулинов, уровень их снижается, пик минимума выявляется в З мес. Затем
количество их постепенно увеличивается и достигает нормы взрослых к 2—З годам.
На протяжении 1-го года жизни ребенка фракции глобулинов претерпевают
сложные и неоднородные изменения: снижение содержания глобулинов у
грудных детей приводит к относительному увеличению количества альбуминов,
которое сильнее всего выражено ко второму месяцу.
12.
Количество крови у новорожденных детей — около 0,5л, ноколичество крови у новорожденных, приходящееся на единицу массы тела,
больше, чем у взрослых. Масса крови по отношению к массе тела
составляет у новорожденных в среднем 15% (11—20%), у грудных детей—
11% (9—1З%), у взрослых— 7% (6—8%). У мальчиков относительное
количество крови несколько больше, чем у девочек.
Доля объема крови, приходящееся на форменные элементы получила
название гематокритного числа или гематокрита.
У взрослых мужчин он составляет 40-50%,
у женщин - 35-45%,
у новорожденных 45-60%,
у детей до 10 лет - 35%.
В 1-й день после рождения гематокритное число выше, чем у
взрослых — в среднем 54%. Это обусловлено высокой концентрацией
эритроцитов. К 5—8-му дню после рождения гематокритное число
снижается до 52%, к концу 1-го месяца — до 42%. у годовалого ребенка
объем форменных элементов составляет 35%,в 5 лет – 37%, в 11—15 лет
— 39%. Нормальные для взрослых величины устанавливаются по
завершении пубертатного периода.
13.
Доля объема крови, составляющая форменныеэлементы называют
гематокритным числом
или
гематокритом.
У мужчин он составляет 40-50%,
у женщин 35-45%,
у новорожденных 45-60%,
у детей до 10 лет – 35%.
КОНЦЕНТРАЦИЯ ФОРМЕННЫХ ЭЛЕМЕНТОВ КРОВИ
В РАСЧЕТЕ НА
1 МКЛ ИЛИ 1 Л КРОВИ
- НАЗЫВАЮТ
ГЕМОГРАММОЙ
14.
Эритроцит и впрямь смешон:Всех органоидов лишён.
Навеки быть ему судьбина
Контейнером гемоглобина.
А.Г. Кнорре
Гликокаликс плазмолеммы
содержит мембранные гликопротеиды –
аглютиногены А и В, определящие
групповую принадлежность.
Наличие в гликокаликсе
агглютиногена Rh-фактора резус положительный индивидуум
при отсутствие его –
резус отрицательные.
В плазме крови циркулируют антитела
- антиА и антиВ
ЭРИТРОЦИТЫ
ФОРМА – ДВОЯКОВЫПУКЛЫЙ ДИСК,
КОТОРАЯ ОБЕСПЕЧИВАЕТ:
- УВЕЛИЧЕНИЕ ИХ ПОВЕРХНОСТИ;
- СНИЖЕНИЕ ДИФФУЗНОГО РАССТОЯНИЯ;
- ВОЗМОЖНОСТЬ УВЕЛИЧЕНИЯ ОБЪЕМА;
- СПОСОБНОСТЬ К ОБРАТИМОЙ ДЕФОРМАЦИИ
РАЗМЕРЫ
НОРМОЦИТЫ: 7,0 – 8,0 МКМ
КОЛИЧЕСТВО
МАКРОЦИТЫ: БОЛЕЕ 9,0 МКМ
МИКРОЦИТЫ: 6,0 МКМ И МЕНЕЕ
МУЖ. 4,0 - 5,5 10¹² /л
ЖЕН. 3,7 – 4,5 10¹² /л
15.
ПОЙКИЛОЦИТОЗ наличие в крови эритроцитов необычной формы.эхиноциты
ЭХИНОЦИТЫ
сфероциты
СФЕРОЦИТЫ
16.
АНИЗОЦИТОЗРАЗЛИЧИЯ В РАЗМЕРАХ
ОТДЕЛЬНЫХ
ЭРИТРОЦИТОВ В МАЗКЕ
микроцит
мегалоцит
17.
ГЕМОГЛОБИН- А1
ОКСИГЕМОГЛОБИН;
- А2
ВОССТАНОВЛЕННЫЙ (РЕДУЦИРОВАННЫЙ);
- ЭМБРИОНАЛЬНЫЙ
КАРБОГЕМОГЛОБИН (С СО2) ОБРАЗУЕТСЯ
10-20%
-ФЕТАЛЬНЫЙ
ткани
легкое
плазма
Н2О
CО2
+ Н2О
карбогидраза
Н2СО3 НСО3
угольная
кислота
бикарбонатный
ион
НСО3
Н2СО3
СО2
Преобразования углекислого газа эритроцитами
18.
• У доношенных новорожденных детей HbF составляетоколо 70%, остальное количество представлено НbА.
• НbF обладает значительно большим сродством к кислороду, чем
НbА.
• После рождения НbF заменяется на НbА. В конце 2-й недели НbА
составляет около 50% общего количества гемоглобина. У детей в
возрасте 35—40 дней подавляющее количество гемоглобина
представлено НbА.
• Кровь новорожденных содержит очень большое количество
гемоглобина: через 1 ч после рождения оно составляет в среднем
208г/л. Наибольшее количество гемоглобина отмечается в
течение первого дня постнатальной жизни, в среднем 214г/л. Со 2го дня количество гемоглобина начинает снижаться и к 9—15-му
дню составляет 190г/л , а в возрасте 1 месяца — 145г/л.
Уменьшение содержания гемоглобина продолжается на
протяжении первого полугодия после рождения, достигая
минимальных величин (120 г/л) к 7-му месяцу. Количество
гемоглобина остается низким до 1 года, затем он постепенно
возрастает и после 15 лет достигает величин свойственных
взрослым (120—140 г/л у женщин, 130—160 г/л у мужчин).
19.
• В момент рождения концентрация эритроцитов несколько выше,чем у взрослого, а именно 5,3-6,0·10·¹²/л. В первые часы жизни
повышается концентрация эритроцитов до 7,5. Со второго дня
жизни начинается постепенное уменьшение количества
эритроцитов и к 10-14 дню жизни уровень эритроцитов достигает
нормы взрослого человека и продолжает снижаться.
• Минимальная концентрация эритроцитов наблюдается обычно
на 3-й 6-й месяцы жизни. Это явление называют физиологической
анемией, считается нормой и не требует врачебного
вмешательства.
• Интенсивное разрушение и образование эритроцитов у
новорожденных, вероятно, необходимы для смены фетального
гемоглобина на гемоглобин взрослых.
• Разрушение эритроцитов у большинства новорожденных
сопровождается физиологической желтухой. Она появляется на 2—
3-й день и исчезает к 7-10-му дню после рождения. Желтуха
обусловлена увеличением концентрации билирубина в плазме крови,
образующегося из гемоглобина разрушенных эритроцитов, и
отложением его в коже.
20.
Средняя продолжительность жизни эритроцитов в периоде новорожденности
меньше, чем у взрослых. У детей на 2—3-й день после рождения она
составляет 12 дней, к 10-му дню увеличивается почти в З раза. У детей старше
1 года длительность жизни эритроцитов приблизительно такая же, как у
взрослых (около 120 дней).
Предполагают, что малая продолжительность жизни эритроцитов у
новорожденных связана с недостаточной способностью их к деформации, т.к.
у новорожденных большое количество макроцитов и сфероцитов.
Деформация эритроцитов необходима для их прохождения через
кровеносные капилляры.
Диаметр эритроцита у новорожденных значительно варьируют от 3 до 10
мкм – т.е. мы наблюдаем анизоцитоз. В месте с тем диаметр эритроцитов
детей первых дней жизни несколько больше, чем у взрослых. При
исследовании эритроцитов в сканирующем электронном микроскопе
установлено, что у детей при рождении примерно 8% эритроцитов имеют
ненормальную форму – куполообразную, стомацитарную, эхиноцитарную,
сфероцитарную. Количество таких эритроцитов к концу первой недели
снижается до 5%. В первые дни после рождения велико содержание
ретикулоцитов. Их количество уменьшается с 4,5% в первые 6-12 часов до
3,6% ко 2-му дню и до 0,6% к 8-му дню жизни. В крови взрослого человека
содержится до 1% ретикулоцитов.
21.
Разрушение гемоглобина приводит к образованию нескольких пигментов гематоидин,
гемосидерин, ферритин.
Гемосидерин – водорастворимый железосодержащий эндогенный пигмент
коричневого цвета, который встречается в виде гранул, ограниченных мембраной в
цитоплазме макрофагов. В них находятся плотно упакованные частицы ферритина.
Гемосидерин образуется при разрушение гемаглобина макрофагами. В норме он
присутствует в малых количествах в макрофагах селезенки, клетках Купфера и
ретикулярных клетках. Он служит резервом железа в организме.
Ферритин, находясь в циркуляции связывается с родственным железу глобулином
плазмы крови – трансферритином, тем самым являясь хранителем железа.
Гематоидин – желто-коричневый эндогенный, не содержащий железа пигмент,
Образующийся при ферментном расщеплении гемоглобина макрофагами. Гематоидин
диффундируется из макрофагов и растворяется в крови, откуда захватывается
гепатоцитами и экскретируется в составе желчных пигментов. Желчные пигменты –
группа свободных от железа пигментов. Сначала образуется биливердин, который
затем полностью переходит в билирубин.
22.
1% ОБЩЕГО ЧИСЛАЭРИТРОЦИТОВ
ПЕРИФЕРИЧЕСКОЙ КРОВИ –
РЕТИКУЛОЦИТЫ
ПРИ ОКРАСКЕ МЕТИЛЕНОВЫМ
СИНИМ В ЦИТОПЛАЗМЕ
ВЫЯВЛЯЮТСЯ ГРАНУЛЫ ИЛИ
СЕТОЧКА – ОСТАТКИ ОРГАНЕЛЛ.
РЕТИКУЛОЦИТЫ
РЕТИКУЛОЦИТЫ ЯВЛЯЮТСЯ
МОЛОДЫМИ ФОРМАМИ
ЭРИТРОЦИТОВ.
23.
ТРОМБОЦИТЫ (КРОВЯНЫЕ ПЛАСТИНКИ)ТРОМБОЦИТОПЕНИЯ – падение содержания
В диаметре 2 – 4 мкм.
Количество 200-400 тыс./мкл
2/3 циркулирует в крови ;
1/3 в красной пульпе селезенки
тромбоцитов ниже 100 тыс./мкл.
(при угнетении образования, усиленном разрушении)
ТРОМБОЦИТОЗ – увеличение выше 600 тыс./мкл.
(при болевом стрессе, в условиях высокогорья, после
спленэктомии).
функции тромбоцитов
остановка кровотечения при повреждении
стенки сосуда (первичный гемостаз);
- обеспечение свертывания крови
(вторичный гемостаз);
- участие в реакции заживления ран и
воспаления;
- ангиотрофическая.
24. Кровяная пластинка
гликокаликсHLA-антиген
Агглютиногены А В 0
микротрубочки
миозиновые филаменты
Rh-фактор
Специфичный
тромбоцитарный
антиген
грануломер
система трубочек
Рецепторы к
иммуноглобулинам
гиаломер
плотные гранулы
микротрубочки
Рецептор к компоненту
комплемента
ФОРМЫ КРОВЯНЫХ ПЛАСТИНОК:
-ЗРЕЛЫЕ – НОРМОЦИТЫ, ОПИСАНИЕ КОТОРЫХ БЫЛО ПРЕДСТАВЛЕНО;
-ЮНЫЕ – НЕМНОГОЧИСЛЕННЫЕ, БОЛЬШИХ РАЗМЕРОВ;
СТАРЫЕ – ОКРУГЛОЙ , ЗУБЧАТОЙ ФОРМЫ С ГРУБОЙ ЗЕРНИСТОСТЬЮ ИЛИ
ВАКУОЛЯМИ;
ФОРМЫ РАЗДРАЖЕНИЯ – КРУПНЫЕ, ВЫТЯНУТЫЕ С НЕРАВНОМЕРНОЙ
ЗЕРНИСТОСТЬЮ
25.
Тромбоцит (кровяная пластинка)Грануломер
(хромомер)
гиаломер
гиалоплазма
митохондрии,
гр.ЭПС,
КГ,
зерна гликогена
Цитоскелетные
структуры
гранулы
АЛЬФА (крупные) – фибриноген, фибронектин, тромбоспондин,
фактор свертывания, тромбоцитарный ФР.
ДЕЛЬТА – кальций, магний, серотонин, гистамин, АТФ, пирофосфат.
ЛЯМБДА - лизосомы
26.
Активация тромбоцитовсопровождается изменением их
формы из дисковидной в
шаровидную и перемещением гранул
в центральную часть, затем адгезия
пластинок к стенке поврежденного
сосуда с последующей их агрегацией.
Не менее важной функцией
является ангиотрофическая,
нарушение которой ведет к
повышению сосудистой
проницаемости и возникновению
геморрагий.
ПРОЦЕСС
СВЕРТЫВАНИЯ В
ТРАВМИРОВАННОМ
СОСУДЕ
Тромбоциты могут быть и
истинными фагоцитами. Ряд
исследователей уверены в функции
тромбоцитов в удаления инородного
материала из крови.
Тромбоциты способны
фиксировать на поверхности
антитела.
27.
• После рождения концентрация тромбоцитов в кровитакая же, как у взрослых или несколько ниже.
• К 7—9-му дню после рождения концентрация
тромбоцитов снижается (до 164—178·10·9/л), а к концу
2-й недели вновь возрастает до первоначальной
величины. В дальнейшем концентрация тромбоцитов
изменяется незначительно. Чем младше ребенок тем
больше у него содержание юных форм тромбоцитов.
• При повреждении кровеносных сосудов происходит
агрегация тромбоцитов. У новорожденных детей она
выражена слабее, чем у взрослых;
• для завершения процесса агрегации требуется больше
времени, а количество тромбоцитов, которые
подвергаются агрегации, меньше.
28. лейкоциты
Палочкоядерныйнейтрофил
Агранулоциты:
моноциты (6-8%)
лимфоциты (20-35%)
Гранулоциты:
нейтрофилы (65-75%)
Характеристика гранулоцитов:
эозинофилы (3-5%)
-наличие гранул
- специфических (нейтрофильные,
эозинофильные, базофильные)
неспецифических (лизосомы)
базофилы (0-1%)
-форма ядер
-неспособность к делению
-работают вне кровеносного русла.
29. Нейтрофильные лейкоциты
количество:Нейтрофильные лейкоциты
юные – 0,5%
палочкоядерные – 3-5%
сегментоядерные – 60-65%
размеры: 10-12 мкм
Циркулирующий пул -1/3; пристеночный – 2/3 количества
Гранулы нейтрофилов:
первичные (азурофильные), крупные, содержаткислую фосфатазу, лизоцим, катионные белки, белкидефензины.
Размеры в мазке – 10-12 мкм
вторичные: - мелкие (90%), содержат щелочную
фосфатазу, катионные белки, лизоцим, лактоферрин,
коллагеназу.
третичные: мелкие, содержат желатиназу (облегчают
прохождение через стенку сосудов).
Формула АРНЕТА – соотношение нейтрофилов в
зависимости от количества сегментов ядра
Палочкояд. 2-х
3 –х
4–х
5 – ое
5%
41%
17%
2%
35%
30. ФУНКЦИИ НЕЙТРОФИЛОВ
фагоцитарная (ПРОФЕССИОНАЛЬНЫЙФАГОЦИТ) – ГЛАВНЫЕ КЛЕТКИ
НЕСПЕЦИФИЧЕСКОЙ ЗАЩИТЫ;
образование антимикробных соединений
-секреция антимикробных веществ – лизоцим,
лактоферрин, дефензин;
- катионные белки (повышают сосудистую проницаемость,
способствуют выделению гистамина базофилами и тучными клетками,
способствуют адгезии и экстраваскулярной миграции лейкоцитов);
- выработка цитокинов:
- разрушение и переваривание поврежденные клеток
и тканей.
31.
Эозинофильные гранулоцитыКоличество в периферической крови -3-5%
(на один эозинофил крови приходится
100-300 в тканях)
Размеры в мазке – 12-15 мкм
Специфические гранулы:
-главный основной белок, содержащих высокие
концентрации аргинина обладает антигельминтным
антипротозойным и антибактериальными эффектами
- катионный белок (антигельминтный, антипротозойный,
антибактериальный эффект);
- пероксидаза (антимикробная и антибактериальная активность)
- нейротоксин антипаразитарное действие
- гистоминаза
- неспецифические гранулы- лизосомы
32.
Функции эозинофиловФАГОЦИТИРУЮТ И АДСОРБИРУЮТ НА ПЛАЗМОЛЕММЕ ГИСТАМИН И
СЕРОТОНИН, ВЫДЕЛЯЕМЫЕ БАЗОФИЛАМИ И ТУЧНЫМИ КЛЕТКАМИ;
ВЫДЕЛЯЮТ ФЕРМЕНТЫ, РАСЩЕПЛЯЮЩИЕ ГИСТАМИН И СЕРОТОНИН
ВНЕКЛЕТОЧНО;
ВЫДЕЛЯЮТ ФАКТОРЫ, ПРЕПЯТСТВУЮЩИЕ ВЫБРОСУ ГИСТАМИНА И
СЕРОТОНИНА БАЗОФИЛАМИ И ТУЧНЫМИ КЛЕТКАМИ;
СПОСОБНЫ ФАГОЦИТИРОВАТЬ БАКТЕРИИ В НЕЗНАЧИТЕЛЬНОМ КОЛИЧЕСТВЕ.
33. Базофильные гранулоциты
Количество: 0-1%, 20-80 клеток/мклРазмеры: 9-12 мкм
Гранулы содержат:
- сульфатированные гликозаминогликаны;
- гепарин;
- хондроитинсульфат:
- гистамин;
- хемотаксические факторы
Функции:
- ферменты
- протеаза, пероксидаза.
- регуляторная
гомеостатическая
- защитная (секреция
медиаторов воспаления)
34.
АНТИГЕН(аллерген)
УЧАСТИЕ БАЗОФИЛОВ И
ЭОЗИНОФИЛОВ
В
АЛЛЕРГИЧЕСКИХ
РЕАКЦИЯХ
ПЛАЗМОЦИТ
IgЕ
IgЕ
базофил
синтез IgЕ
IgЕ
IgЕ
тучная клетка
ДЕГРАНУЛЯЦИЯ
Хемотаксическое влияние
ГИСТАМИН,
СЕРОТОНИН,
БРАДИКИНИН,
ПРОСТАГЛАНДИНЫ,
ЛЕЙКОТРИЕНЫ.
эозинофил
Миграция эозинофилов,
захват гранул
Переваривание продуктов
дегрануляции –
ослабление аллергических реакций
Развитие аллергических реакций – увеличение
проницаемости кровеносных сосудов, увеличение
процессов секреции, возрастание
сократительной активности гладких миоцитов
бронхов, пищеварительного тракта.
35.
36.
ДВИЖЕНИЕ НЕЙТРОФИЛОВ ПУТЕМ ДИАПЕДЕЗА ЧЕРЕЗ ПОРЫ КАПИЛЛЯРОВ И ПУТЕМХЕМОТАКСИСА К ОБЛАСТИ ПОВРЕЖДЕНИЯ ТКАНИ.
ВЫХОЖДЕНИЕ ФОРМЕННЫХ
ЭЛЕМЕНТОВ КРОВИ ЧЕРЕЗ
НЕПОВРЕЖДЕННЫЕ СТЕНКИ
КАПИЛЛЯРОВ И МЕЛКИХ ВЕН
СТАДИИ МИГРАЦИИ ЛЕЙКОЦИТОВ
1 обратимое связывание с эндотелием посредством
белков селектинов.
2 транзиторная адгезия – качение. Обусловлено
активацией эндотелия сосудов (расположенных вблизи
повреждения) цитокинами и медиаторами воспаления,
вызывающая активацию поверхностных адгезивных
белков. Этот процесс является обратимым - быстро
блокируется инактивацией селектинов.
3 при продолжающейся стимуляции эндотелия и
лейкоцитов цитокинами плюс присоединение
хемотаксических цитокинов – хемокинов лейкоцит
распластывается на поверхности эндотелия благодаря
адгезивным белкам: интегринам, селектинами
иммуноглобулиноподобных адгезивных белков.
4 миграция лейкоцитов через эндотелий.
5 миграция лейкоцита к очагу поражения.
КРАЕВОЕ РАСПОЛОЖЕНИЕ.
37.
Размеры -18-20 мкмКоличество: 240-700клеток/мкл, 6-8%
моноциты
КРАСНЫЙ КОСТНЫЙ МОЗГ
СТВОЛОВАЯ КЛЕТКА
МОНОЦИТОПОЭЗ
АЛЬВЕОЛЯРНЫЕ
МОНОЦИТЫ
(КРОВЬ)
МОНОНУКЛЕАРНАЯ
ФАГОЦИТАРНАЯ СИСТЕМА
МАКРОФАГИ
(ТКАНИ)
КОСТНОГО МОЗГА
ЛИМФАТИЧЕСКИХ УЗЛОВ
СЕЛЕЗЕНКИ
СЕРОЗНЫХ ПОЛОСТЕЙ
ГИСТИОЦИТЫ
КУПФЕРА КЛЕТКИ
Денгдритные
антигенпредставляющие
клетки
МИКРОГЛИЯ
ОСТЕОКЛАСТЫ
СИНОВИАЛЬНЫЕ
А- КЛЕТКИ
38.
моноцитФункции моноцитов
- обеспечение реакции неспецифической
макрофаг
защиты
- участие в иммунных реакциях;
- макрофагальная;
- секреция регуляторов межклеточного
вещества:
- лизосомальные протеазы,
- коллагеназы,
- эластазы,
- активатор плазминогена;
- активаторы клеток – монокины (циклины)
39.
ЛИМФОЦИТКоличество: 1000-3000 клеток/мкл
20-35%
Размеры: малые - 6-7мкм,
средние - 8-9 мкм
большие –10-18 мкм
Функции лимфоцитов
Иммунная реакция:
- гуморальный;
- клеточный
Секреция лимфокинов
(цитокинов)
Классификация лимфоцитов
по
функциональному признаку:
Т- лимфоциты
В – лимфоциты
О - лимфоциты
40.
Лимфоцит – ну и творит дела!Фабрикует он антитела.
Только неучи ему всерьез
Могут приписать фагоцитоз.
А.Г. Кнорре
Микроотростчатый тип, или В-клетки
Сглаженный тип, или Т-клетки
• ЦИРКУЛЯЦИЯ лимфопоэтических клеток и лимфоцитов через различные
лимфопоэтические органы и ткани с кровью и лимфой.
• Медленная циркуляция - движение недифференцированных лимфоцитов
через костный мозг в кровеносное русло а оттуда в тимус и лимфоидные
узелки, где они становятся зрелыми иммунокомпетентными В- и Т лимфоцитами. Вновь попадая в кровоток, лимфоциты блуждают в тканях,
оттуда собираются афферентными лимфатическими сосудами переносятся с
лимфой в лимфатические узлы. Через эфферентные лимфатические сосуды
лимфоциты вновь попадают в кровоток, затем в ткани и весь цикл снова
повторяется. Медленная циркуляция длится несколько недель.
41.
КОСТНЫЙ МОЗГЛИМФОЦИТ
НЕДИФФЕРЕНЦИРОВАННЫЙ
ЦИРКУЛЯЦИЯ
ЛИМФОЦИТОВ
К
Т
Р
О
ТКАНИ
В
В
О
Т
АФФЕРЕНТНЫЕ
ЛИМФАТИЧЕСКИЕ
СОСУДЫ
В
АНАЛОГ СУМКИ
Т
О
К
РЕЦИРКУЛЯЦИЯ
ЛИМФОЦИТОВ
ЛИМФАТИЧЕСКИЕ
УЗЛЫ
В Т
ЭФФЕРЕНТНЫЕ
ЛИМФАТИЧЕСКИЕ
СОСУДЫ
ТИМУС
42.
РЕЦИРКУЛЯЦИЯ ЛИМФОЦИТОВ быстрая циркуляция, (миграция лимфоцитов
из крови в ткани и органы лимфопоэза, а оттуда снова в кровь).
ПУТИ: В- и Т - лимфоциты, циркулирующие в тканях, возвращаются в
лимфатические узлы через афферентные лимфатические сосуды, проходят
через синусы и паренхиму узлов по эфферентным лимфатическим сосудам
попадают в грудной проток, из которых они переносятся в кровь,
распределяясь по тканям и лифопоэтическим органам. В лимфатических
узлах, пройдя через него собираются эфферентными сосудами. В селезенке
лимфоциты также циркулируют через паренхиму и покидают через
лимфатические и кровеносные сосуды. Через тимус циркуляции нет, тимус
является органом продуцирующим Т-лимфоциты.
РЕЦИРКУЛЯЦИЯ через кровь длится 10мин, пассаж через селезенку около 6
часов, а через лимфатические узлы -15-20 часов. В это время лимфоциты
делятся. Большие лимфоциты - иммунобласты не рециркулируют.
ЦЕЛЬ рециркуляции и постоянное патрулирование компетентных лимфоцитов
по организму и информирование иммунокомпетентных органов о наличие
или отсутствие антигенов в нем. В присутствие антигенов некоторые
лимфоциты оседают, начинают делиться и запускают иммунный ответ.
Утерянные клетки пополняются за счет вновь образованных в красном
костном мозге, тимусе и лимфоидных органах.
43.
МАРКЕРЫ ПЛАЗМОЛЕММЫПОВЕРХНОСТНЫЕ
ФУНКЦИОНАЛЬНЫЕ
МАРКЕРЫ ПЛАЗМОЛЕММЫ
МАРКЕРЫ
ПЛАЗМОЛЕММЫ
В-ЛИМФОЦИТОВ
МАРКЕРЫ
ПЛАЗМОЛЕММЫ
В-ЛИМФОЦИТОВ
В-ЛИМФОЦИТОВ
МАРКЕРЫВ-ЛИМФОЦИТОВ
ЛИМФОЦИТОВ
ОБОЗНАЧАЮТСЯ
КАК CD-МОЛЕКУЛЫ
(Clusters of Differentiation)
C ДОБАВЛЕНИЕМ НОМЕРОВ И
БУКВЕННЫХ СИМВОЛОВ.
44. Маркеры плазмолеммы В - лимфоцитов
ИММУНОГЛОБУЛИНЫ (Ig…).CD 19, CD 20, CD 22 – ОБЩИЕ
CD 21, CD 35 - АКТИВНЫЕ
45.
МАРКЕРЫ ПЛАЗМОЛЕММЫТ-ЛИМФОЦИТОВ
ТКР – Т-клеточные рецепторы
CD 2, CD 3 - ОБЩИЕ
CD 4 – Т-ХЕЛПЕРЫ.
CD 8 – Т-СУПРЕССОРЫ И КИЛЛЕРЫ.
46.
У новорожденного концентрация лейкоцитов колеблется в широких пределах, но
всегда превышает норму взрослого. В первые часы жизни число лейкоцитов
несколько увеличивается, а затем в течении 1-2 дней быстро падает ( примерно до
15 тыс.). К 5-12 дню количество лейкоцитов снижается до 9 тыс. и к 14-15 дню
концентрация лейкоцитов доходит до уровня взрослого. У новорожденных детей
соотношение между нейтрофилами и лимфоцитами примерно такое же, как у
взрослых. Вскоре количество нейтрофилов начинает быстро убывать, а количество
лимфоцитов – расти.
К 3-7 дням жизни оба показателя уравниваются. Это называется «первый
физиологический перекрест лейкоцитов». Процент лимфоцитов и далее
продолжает повышаться, а процент нейтрофилов снижается. К концу второго
года жизни содержание лимфоцитов начинает уменьшаться, а нейтрофилов
расти. Это приводит к тому, что на 4-м году жизни отмечается повторное
равновесие между лимфоцитами и нейтрофилами. Это называется «второй
физиологический перекрест лейкоцитов».
Следует иметь в виду склонность показателей крови детей к широким
индивидуальным колебаниям. Кроме того на содержание лейкоцитов могут
оказывать влияние кормление, плач, моторное беспокойство. Среди особенностей
реакции системы крови детей давно подмечена склонность к образованию очагов
экстрамедуллярного гемопоэза. Возможность возникновения экстрамедуллярного
гемопоэза объясняется малой степенью дифференцировки ретикулярной ткани в
организме ребенка.
47.
Лейкоцитарная формула у детейЛейкоцитарная формула у детей имеет существенные различия в
зависимости от возраста. Для лейкоцитарной формулы новорожденного (за
исключением первых дней жизни, когда отмечается нейтрофилез)
характерен стойкий лимфоцитоз как относительный, так и абсолютный (см
таблицу). У новорожденного процент лимфоцитов, постепенно
увеличиваясь, доходит к 5-му дню до 50—60, а процент нейтрофилов к
этому же времени постепенно снижается до 35—47.
Если изобразить изменения количества нейтрофилов и лимфоцитов в виде кривых
(рис.), то приблизительно между 3—5-м днем отмечается пересечение кривых —
так называемый первый перекрест. К концу первого месяца жизни у ребенка
устанавливается лейкоцитарная формула, характерная для всего первого года
жизни. Лейкоцитарная формула грудных детей отличается некоторой
лабильностью; она сравнительно легко нарушается при сильном плаче и
беспокойстве ребенка, резких переменах диеты, охлаждении и перегревании и
особенно при различных заболеваниях.
В дальнейшем, на 3—6-м году жизни значительно уменьшается количество
лимфоцитов и нарастает количество нейтрофилов. Соответствующие кривые
нейтрофилов и лимфоцитов снова перекрещиваются — второй перекрест. В
возрасте 14— 15 лет Лейкоцитарная формула детей почти полностью
приближается к лейкоцитарной формуле взрослых.
48.
ДИНАМИКА ЛЕЙКОЦИТОВ КРОВИВ ПОСТНАТАЛЬНОМ ПЕРИОДЕ
ДИНАМИКА ЛЕЙКОЦИТОВ КРОВИ
70
В ПОСТНАТАЛЬНОМ
ПЕРИОДЕ
65
60
65
нейтрофилы
50
65
45
40
45
лимфоциты
30
25
20
25
25
10
0
1
лимфоциты
нейтрофилы
5-62
день
3
4 года
4
5
49.
50.
ОСОБЕННОСТИ СОСТАВА КРОВИВ ПОСТНАТАЛЬНОМ ПЕРИОДЕ
ЭРИТРОЦИТОЗ У НОВОРОЖДЕННЫХ (ДО 6-7 МЛН/МКЛ)
ЛЕЙКОЦИТОЗ У НОВОРОЖДЕННЫХ (ДО 10-30 ТЫС/МКЛ) С
ПОСЛЕДУЮЩИМ СНИЖЕНИЕМ В ТЕЧЕНИЕ 2-Х НЕДЕЛЬ
ФИЗИОЛОГИЧЕСКАЯ АНЕМИЯ В 3-6 МЕСЯЦЕВ
ВОЗРАСТНЫЕ ПЕРЕКРЕСТЫ СОДЕРЖАНИЯ НЕЙТРОФИЛОВ
И ЛИМФОЦИТОВ
51.
ОХ И СЛОЖНОЕ ЭТО ДЕЛО –КРОВЬ…
СПАСИБО ЗА ВНИМАНИЕ
И ТЕРПЕНИЕ…
И ЗА ТИШИНУ В ЗАЛЕ.



















































 Медицина
Медицина